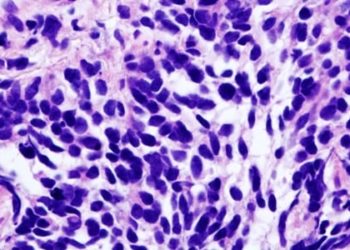
Thoracic radiotherapy improves survival in small-cell lung cancer patients

#VisualAbstract: Neoadjuvant nivolumab plus chemotherapy increases event-free survival in resectable non-small-cell lung cancer
1. Neoadjuvant nivolumab plus chemotherapy led to a longer event-free survival and higher percentage of patients with a pathological complete ...